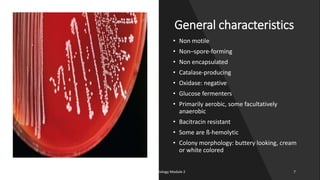
General characteristics
• Non motile
• Non–spore-forming
• Non encapsulated
• Catalase-producing
• Oxidase: negative
• Glucose fermenters
• Primarily aerobic, some facultatively
anaerobic
• Bacitracin resistant
• Some are ß-hemolytic
• Colony morphology: buttery looking, cream
or white colored
8/11/2023 Medical Bacteriology Module 2 7
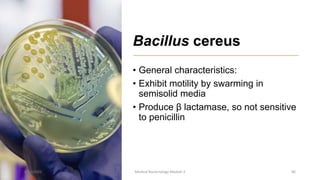
Bacillus cereus
• General characteristics:
• Exhibit motility by swarming in
semisolid media
• Produce β lactamase, so not sensitive
to penicillin
8/11/2023 Medical Bacteriology Module 2 86
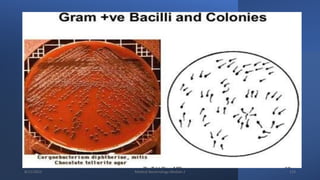
8/11/2023 Medical Bacteriology Module 2 123
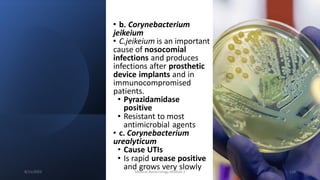
• b. Corynebacterium
jeikeium
• C.jeikeium is an important
cause of nosocomial
infections and produces
infections after prosthetic
device implants and in
immunocompromised
patients.
• Pyrazidamidase
positive
• Resistant to most
antimicrobial agents
• c. Corynebacterium
urealyticum
• Cause UTIs
• Is rapid urease positive
and grows very slowly
8/11/2023 Medical Bacteriology Module 2 124
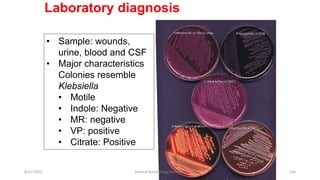
Laboratory diagnosis
• Sample: wounds,
urine, blood and CSF
• Major characteristics
Colonies resemble
Klebsiella
• Motile
• Indole: Negative
• MR: negative
• VP: positive
• Citrate: Positive
8/11/2023 Medical Bacteriology Module 2 146
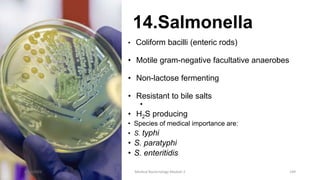
14.Salmonella
• Coliform bacilli (enteric rods)
• Motile gram-negative facultative anaerobes
• Non-lactose fermenting
• Resistant to bile salts
•
• H2S producing
• Species of medical importance are:
• S. typhi
• S. paratyphi
• S. enteritidis
8/11/2023 Medical Bacteriology Module 2 149
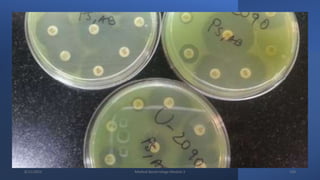
8/11/2023 Medical Bacteriology Module 2 169
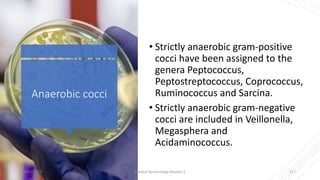
Anaerobic cocci
• Strictly anaerobic gram-positive
cocci have been assigned to the
genera Peptococcus,
Peptostreptococcus, Coprococcus,
Ruminococcus and Sarcina.
• Strictly anaerobic gram-negative
cocci are included in Veillonella,
Megasphera and
Acidaminococcus.
8/11/2023 Medical Bacteriology Module 2 217
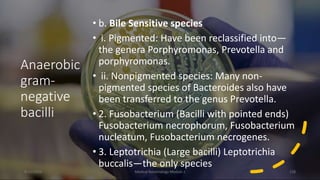
Anaerobic
gram-
negative
bacilli
• b. Bile Sensitive species
• i. Pigmented: Have been reclassified into—
the genera Porphyromonas, Prevotella and
porphyromonas.
• ii. Nonpigmented species: Many non-
pigmented species of Bacteroides also have
been transferred to the genus Prevotella.
• 2. Fusobacterium (Bacilli with pointed ends)
Fusobacterium necrophorum, Fusobacterium
nucleatum, Fusobacterium necrogenes.
• 3. Leptotrichia (Large bacilli) Leptotrichia
buccalis—the only species
8/11/2023 Medical Bacteriology Module 2 228
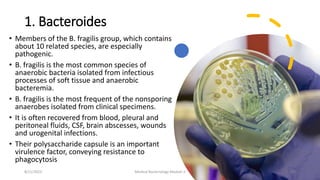
1. Bacteroides
• Members of the B. fragilis group, which contains
about 10 related species, are especially
pathogenic.
• B. fragilis is the most common species of
anaerobic bacteria isolated from infectious
processes of soft tissue and anaerobic
bacteremia.
• B. fragilis is the most frequent of the nonsporing
anaerobes isolated from clinical specimens.
• It is often recovered from blood, pleural and
peritoneal fluids, CSF, brain abscesses, wounds
and urogenital infections.
• Their polysaccharide capsule is an important
virulence factor, conveying resistance to
phagocytosis
8/11/2023 Medical Bacteriology Module 2 229
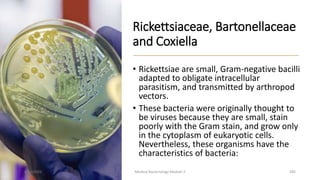
Rickettsiaceae, Bartonellaceae
and Coxiella
• Rickettsiae are small, Gram-negative bacilli
adapted to obligate intracellular
parasitism, and transmitted by arthropod
vectors.
• These bacteria were originally thought to
be viruses because they are small, stain
poorly with the Gram stain, and grow only
in the cytoplasm of eukaryotic cells.
Nevertheless, these organisms have the
characteristics of bacteria:
8/11/2023 Medical Bacteriology Module 2 285
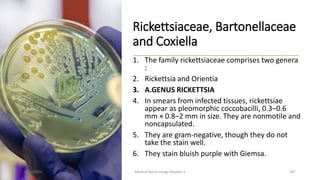
Rickettsiaceae, Bartonellaceae
and Coxiella
1. The family rickettsiaceae comprises two genera
:
2. Rickettsia and Orientia
3. A.GENUS RICKETTSIA
4. In smears from infected tissues, rickettsiae
appear as pleomorphic coccobacilli, 0.3–0.6
mm × 0.8–2 mm in size. They are nonmotile and
noncapsulated.
5. They are gram-negative, though they do not
take the stain well.
6. They stain bluish purple with Giemsa.
8/11/2023 Medical Bacteriology Module 2 287
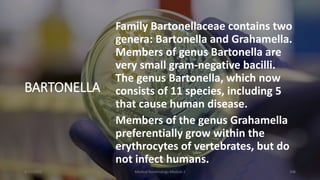
BARTONELLA
Family Bartonellaceae contains two
genera: Bartonella and Grahamella.
Members of genus Bartonella are
very small gram-negative bacilli.
The genus Bartonella, which now
consists of 11 species, including 5
that cause human disease.
Members of the genus Grahamella
preferentially grow within the
erythrocytes of vertebrates, but do
not infect humans.
8/11/2023 Medical Bacteriology Module 2 308
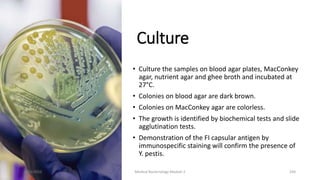
Culture
• Culture the samples on blood agar plates, MacConkey
agar, nutrient agar and ghee broth and incubated at
27°C.
• Colonies on blood agar are dark brown.
• Colonies on MacConkey agar are colorless.
• The growth is identified by biochemical tests and slide
agglutination tests.
• Demonstration of the FI capsular antigen by
immunospecific staining will confirm the presence of
Y. pestis.
8/11/2023 Medical Bacteriology Module 2 334

This document provides an overview of medically important bacteria, organized by their characteristics. It discusses Gram-positive cocci like Staphylococcus and Streptococcus species. S. aureus is described as an important pathogen that can cause skin and bloodstream infections. Its virulence factors include toxins and enzymes. Streptococcus species are classified using Lancefield grouping. S. pyogenes is associated with infections like pharyngitis and impetigo, as well as nonsuppurative sequelae such as rheumatic fever. Laboratory diagnosis and treatment options are also summarized.
![Medical
Bacteriology
[Bacteria causing medically important diseases]
8/11/2023 Medical Bacteriology Module 2 1](https://image.slidesharecdn.com/medicalbacteriology-230811135441-6e46a040/75/Medical-Bacteriology-pptx-1-2048.jpg)